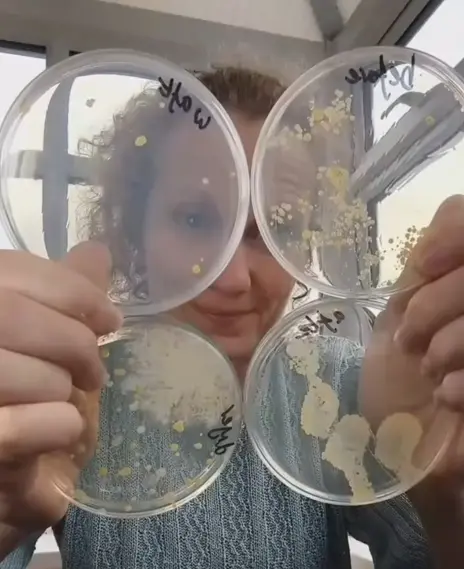
▲Ruth MacLaren 採集了烘手機出風口、廁所空間，以及洗手前、洗手後用烘手機等4個培養皿來對照。（圖／Devon Science TikTok）

(18:45 更新,新增新光醫院家醫科醫師柳朋馳受訪內容)台灣百貨公司、商場、捷運站等許多公共廁所都設有烘手機(hand dryer),被視為是「環保」愛地球的選擇。不過,英國一名科學老師公開1分多鐘的「實驗影片」,對比發現,烘手機吹出的細菌不只比空間細菌多,還會讓洗乾淨的手沾滿細菌,等於白洗。影片觀看次數超過1410萬次,不少人看完直呼:「以後不烘乾手了!」
科學實測曝光:烘手機出風口細菌量遠超廁所空間
英國德文郡一家科學教育機構「Devon Science」近期在TikTok發布烘手機實驗影片,機構主持科學家Ruth MacLaren 先前在烘手機出風口下,放置培養皿(agar plate),測出爆量細菌,吸引2800萬次觀看。
這次她決定進行烘手機快速測驗,採集了烘手機出風口、廁所空間,以及洗手前、洗手後用烘手機等4個培養皿來對照。結果發現,烘手機出風口的培養皿上滿滿的細菌,目測比廁所環境的培養皿細菌還多出許多;而洗手後用烘手機、在手上流下的細菌量跟洗手前差不多,烘乾手等於白洗了。這支影片吸引超過1410萬次觀看。

▲Ruth MacLaren 採集了烘手機出風口(左下)、廁所空間(左上),以及洗手前(右上)、洗手後用烘手機(右下)等4個培養皿來對照。(圖/Devon Science TikTok)
影片被轉載到Threads上引發討論,21小時吸引超過115萬次觀看,網友紛紛留言「就算是有HEPA濾網的烘手我也不想用,我都隔著衛生紙開公廁的門,很奇怪的人」、「看過烘乾機噴過蟑螂出來以後就不用了」、「之前有人拆開烘手機裡面整個黴垢超可怕,我後來都不用了,還有外面的製冰機也是,看過一次真的會嚇爛」。
作家質疑影片採樣方式:濕手恐影響檢驗結果
不過,曾在檢驗業擔任6年水質分析師的作家「愛鯊客」則列出4點說明,他認為影片中烘乾手後的採樣,濕的手會影響檢驗結果;影片中拿培養皿在廁所四處揮舞,因測法不同,無法作為對照組;洗手後按壓培養基的菌其實比洗手前多;以及他個人支持不要用烘手機,用擦手紙會更好。

▲曾任水質分析師的作家「愛鯊客」指出,影片中烘乾手後的採樣,濕的手會影響檢驗結果。(圖/取自Threads)
哈佛、里茲大學研究:烘手機病菌傳播風險高10倍
哈佛健康中心曾發布康乃狄克大學和昆尼皮亞克大學一項研究發現,暴露在廁所烘手機熱風中 30 秒的培養皿中,細菌菌落最多可生長到 254 個,但關閉烘手機的話,培養皿暴露在廁所空氣中2分鐘,只會生長出一個細菌菌落,或者根本沒有細菌生長。
英國里茲大學也曾找來4位受試者分成兩組,在他們手部塗上對人體無害的病毒、穿上圍裙然後洗手。一組用擦手紙,一組用烘手機烘乾。結果發現,用烘乾機烘乾的手接觸過的地方,污染程度是用擦手紙的10倍;而圍裙的污染程度,烘乾機組是衛生紙組的5倍。

▲目前不少公共廁所的烘手機已經改成手往下伸的新型式乾手機。(示意圖/取自photoAC)
烘手機比擦手紙病菌傳播高10倍?醫師這樣說
新光醫院健康管理部醫療副主任、家醫科醫師柳朋馳告訴《NOWNEWS》說,烘手機的溫度不會高到可以滅菌,只是藉由短暫的高溫與強風把水分帶走,所以其實在COVID期間是不建議使用烘手機的,因為如果手上沒有洗乾淨,會在烘手過程中把病毒因為氣流而往外擴散。
至於使用烘手機會不會把原本洗乾淨的手弄「髒」?柳朋馳表示,這取決於機器有沒有人保養、吹風口會不會帶出細菌,以及空間中細菌菌落、落塵等環境情況,都會關係到洗手後用烘乾機會不會更髒。他說明,就像冷氣機沒清洗,裡面有黴菌,那吹出來的風就會導致會導致身上沾附這些細菌。
柳朋馳指出,如果是希望手部能保持完整的乾淨,最重要還是在洗手的當下,「洗乾淨才能讓手上細菌菌落大幅下降」。他表示,上完廁所後要用烘手機還是擦手紙其實沒有對錯,就看個人習慣與偏好,想避免紙張浪費、環保訴求可選擦手紙,喜歡手部完全乾燥感較適合用烘手機。
長庚醫院毒物科醫師顏宗海表示,烘手機和廁所的衛生很有關係,不乾淨的烘手機會擔心藏汙納垢,有些微生物在裡面。台大醫院小兒部主治醫師、中央流行疫情指揮中心諮詢委員李秉穎過去曾表示,烘手機去除病原的效果較差原因,和「風吹細菌」無關,主要烘手時是少了「手部摩擦」的動作。
新型號除菌力更高?業者實測:優於擦手紙97%
不過,專注提供室內空氣品質解決方案的「達冠科技」也曾發布實測影片,找來5款烘手機和擦手紙進行實驗,用池塘水沾手,手中細菌指數高達817RLU,而沾滿池塘水的手經烘手機烘乾後,傳統烘手機的細菌殘留量剩466、擦手機則是97,不過三菱116乾手機的細菌指數只剩24,認為新型的乾手機能夠去除97%手部病菌,除菌力比擦手紙更高。
資料來源:柳朋馳·家醫科醫師的日常 、Devon Science、哈佛健康中心、Threads、達冠科技
我是廣告 請繼續往下閱讀
英國德文郡一家科學教育機構「Devon Science」近期在TikTok發布烘手機實驗影片,機構主持科學家Ruth MacLaren 先前在烘手機出風口下,放置培養皿(agar plate),測出爆量細菌,吸引2800萬次觀看。
這次她決定進行烘手機快速測驗,採集了烘手機出風口、廁所空間,以及洗手前、洗手後用烘手機等4個培養皿來對照。結果發現,烘手機出風口的培養皿上滿滿的細菌,目測比廁所環境的培養皿細菌還多出許多;而洗手後用烘手機、在手上流下的細菌量跟洗手前差不多,烘乾手等於白洗了。這支影片吸引超過1410萬次觀看。
@devonscience Has anything changed? Did that hand dryer get a service or clean? For its viral birthday 🎉 (28M views), I went back and retested THE hand dryer seen by so many, this time I also tested my hands before & after using it. I've identified the main bacterial species growing (they're common environmental bacteria), and they're coming from inside the machine vents (see videos on this). Please see my follow up videos on this which will answer some of your questions, i.e. are the bacteria harmful, what do these results mean, what happens next! Remember this is a quick test, not a scientific experiment, but it could be a great project for someone studying microbiology. I've tested a few different hand dryers over the last 12 months, have a look at the videos on my profile. #handdryer #bacteria #viral #germs #dirty
♬ original sound - Devon Science
作家質疑影片採樣方式:濕手恐影響檢驗結果
不過,曾在檢驗業擔任6年水質分析師的作家「愛鯊客」則列出4點說明,他認為影片中烘乾手後的採樣,濕的手會影響檢驗結果;影片中拿培養皿在廁所四處揮舞,因測法不同,無法作為對照組;洗手後按壓培養基的菌其實比洗手前多;以及他個人支持不要用烘手機,用擦手紙會更好。

哈佛健康中心曾發布康乃狄克大學和昆尼皮亞克大學一項研究發現,暴露在廁所烘手機熱風中 30 秒的培養皿中,細菌菌落最多可生長到 254 個,但關閉烘手機的話,培養皿暴露在廁所空氣中2分鐘,只會生長出一個細菌菌落,或者根本沒有細菌生長。
英國里茲大學也曾找來4位受試者分成兩組,在他們手部塗上對人體無害的病毒、穿上圍裙然後洗手。一組用擦手紙,一組用烘手機烘乾。結果發現,用烘乾機烘乾的手接觸過的地方,污染程度是用擦手紙的10倍;而圍裙的污染程度,烘乾機組是衛生紙組的5倍。

新光醫院健康管理部醫療副主任、家醫科醫師柳朋馳告訴《NOWNEWS》說,烘手機的溫度不會高到可以滅菌,只是藉由短暫的高溫與強風把水分帶走,所以其實在COVID期間是不建議使用烘手機的,因為如果手上沒有洗乾淨,會在烘手過程中把病毒因為氣流而往外擴散。
至於使用烘手機會不會把原本洗乾淨的手弄「髒」?柳朋馳表示,這取決於機器有沒有人保養、吹風口會不會帶出細菌,以及空間中細菌菌落、落塵等環境情況,都會關係到洗手後用烘乾機會不會更髒。他說明,就像冷氣機沒清洗,裡面有黴菌,那吹出來的風就會導致會導致身上沾附這些細菌。
柳朋馳指出,如果是希望手部能保持完整的乾淨,最重要還是在洗手的當下,「洗乾淨才能讓手上細菌菌落大幅下降」。他表示,上完廁所後要用烘手機還是擦手紙其實沒有對錯,就看個人習慣與偏好,想避免紙張浪費、環保訴求可選擦手紙,喜歡手部完全乾燥感較適合用烘手機。
長庚醫院毒物科醫師顏宗海表示,烘手機和廁所的衛生很有關係,不乾淨的烘手機會擔心藏汙納垢,有些微生物在裡面。台大醫院小兒部主治醫師、中央流行疫情指揮中心諮詢委員李秉穎過去曾表示,烘手機去除病原的效果較差原因,和「風吹細菌」無關,主要烘手時是少了「手部摩擦」的動作。
新型號除菌力更高?業者實測:優於擦手紙97%
不過,專注提供室內空氣品質解決方案的「達冠科技」也曾發布實測影片,找來5款烘手機和擦手紙進行實驗,用池塘水沾手,手中細菌指數高達817RLU,而沾滿池塘水的手經烘手機烘乾後,傳統烘手機的細菌殘留量剩466、擦手機則是97,不過三菱116乾手機的細菌指數只剩24,認為新型的乾手機能夠去除97%手部病菌,除菌力比擦手紙更高。



